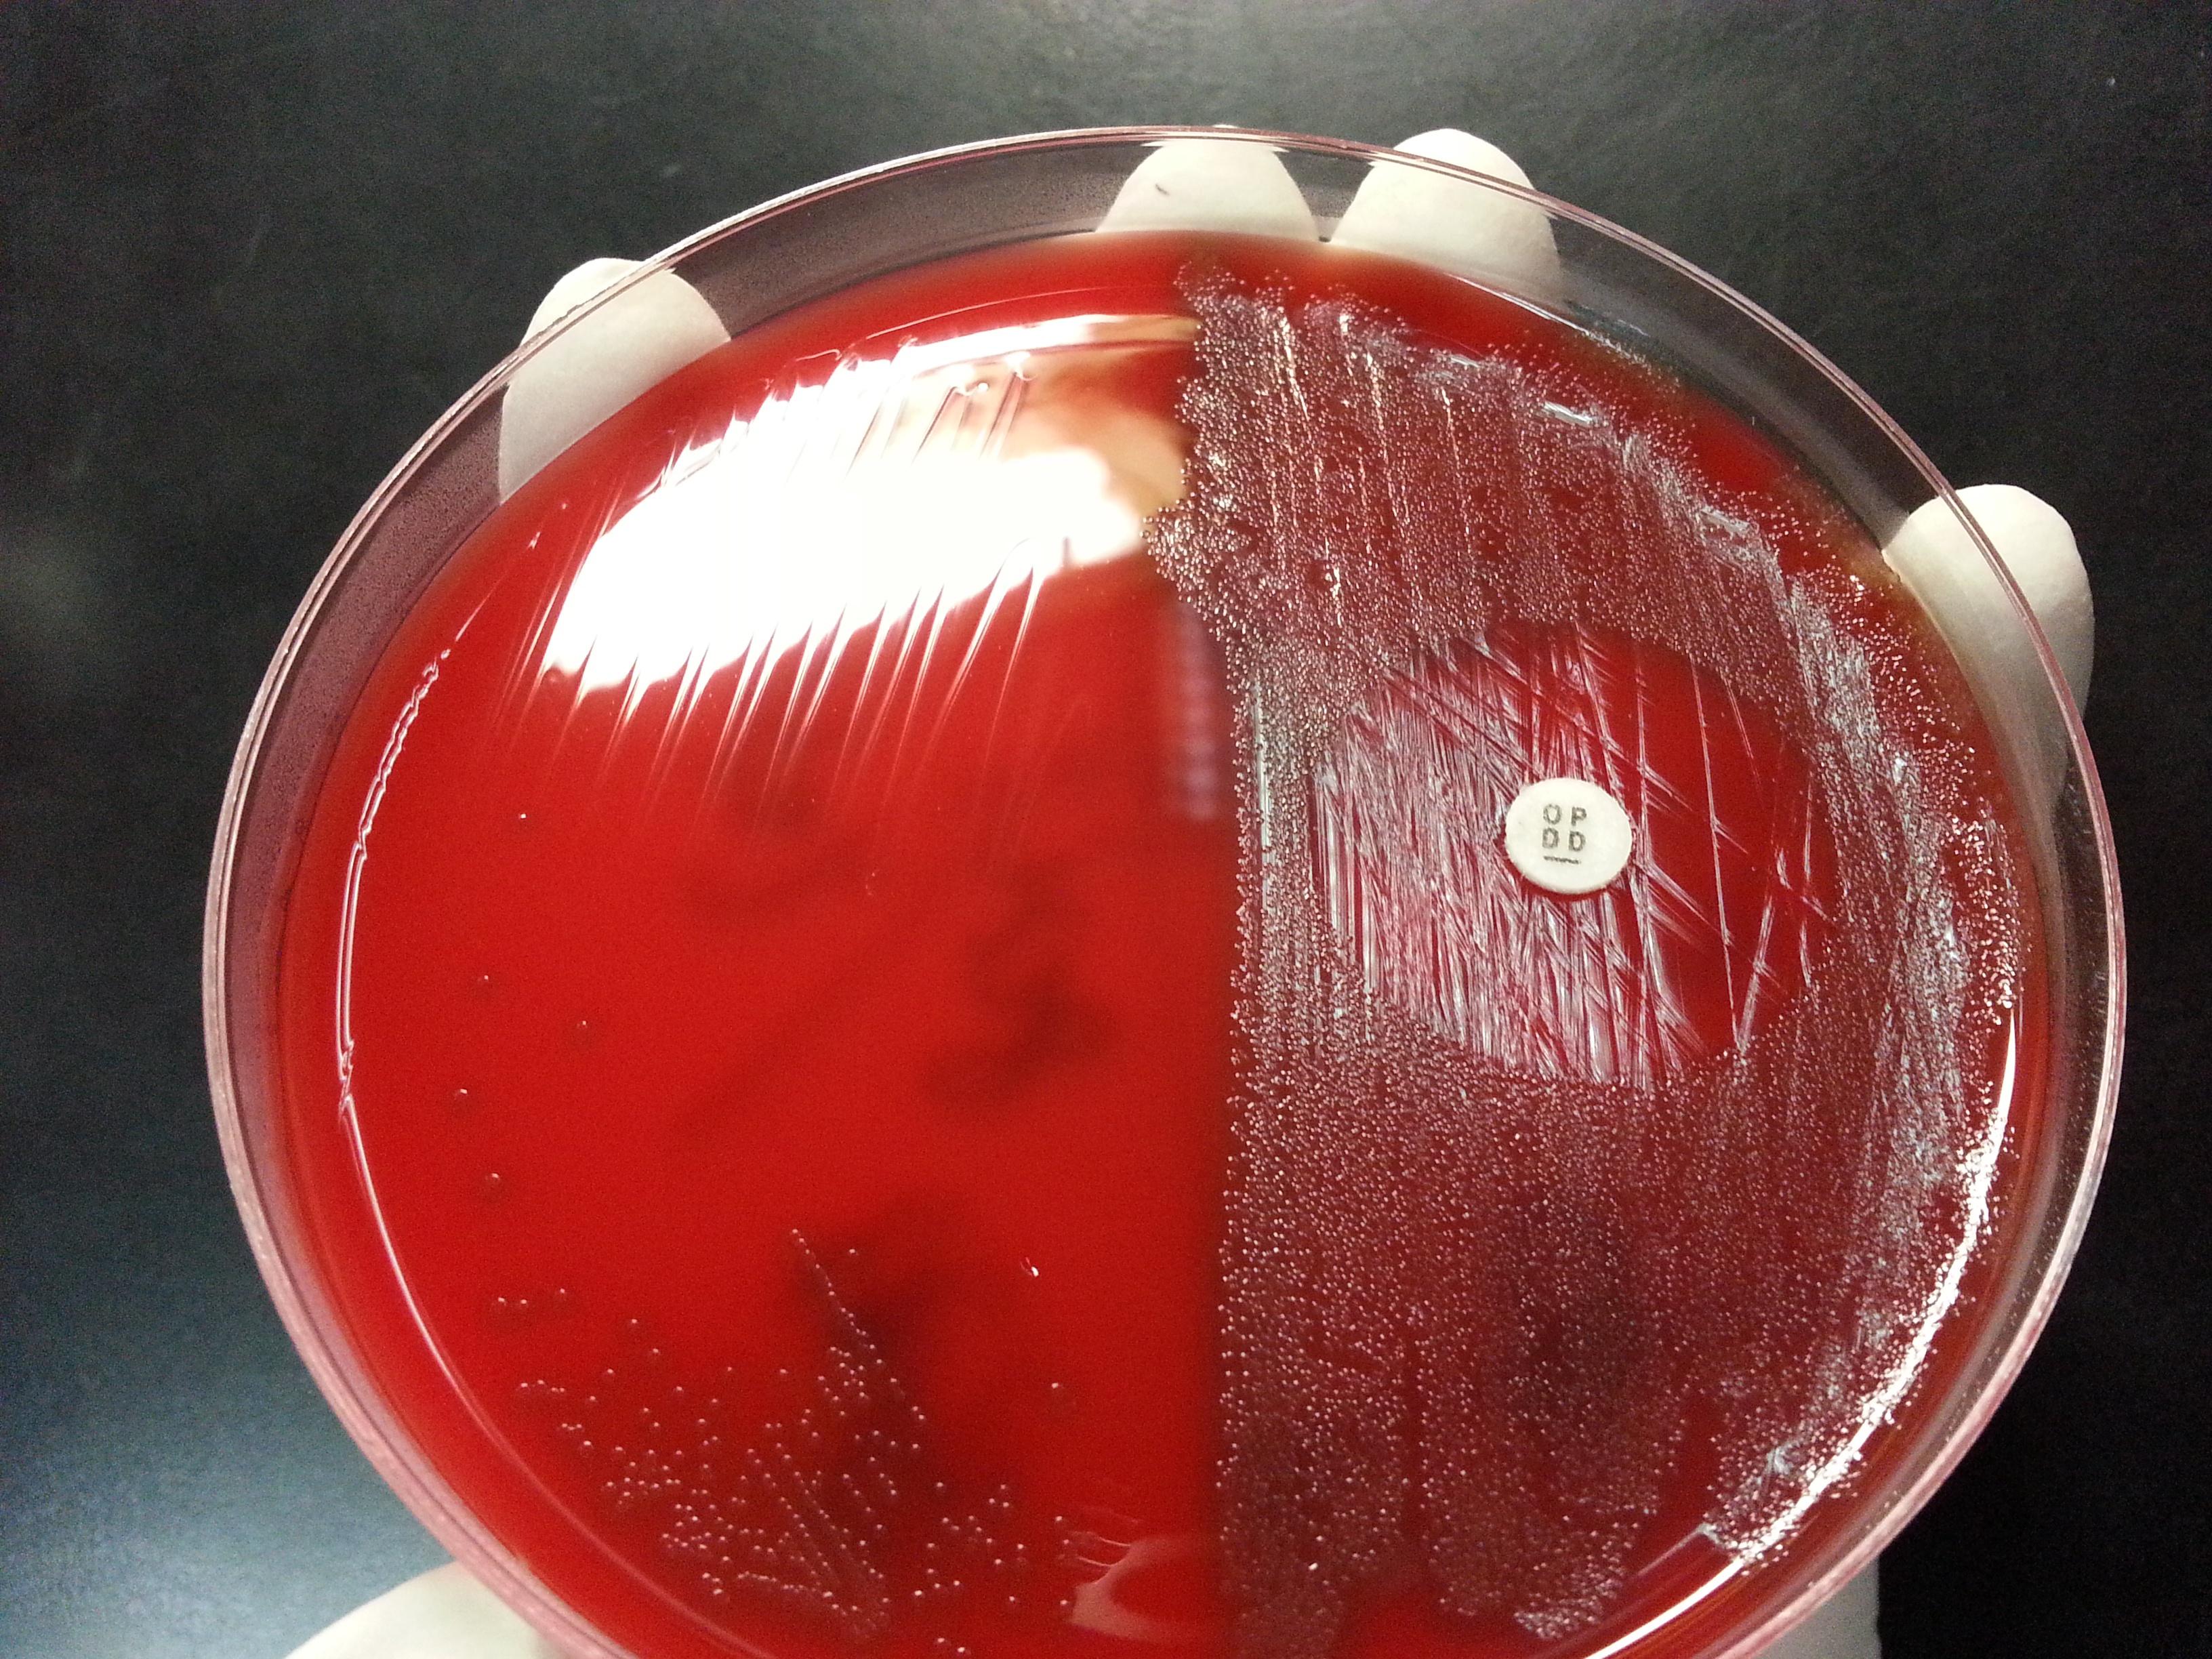
肺炎链球菌op阳性图片一副

新冠肺炎球菌图片

这样的肺炎链球菌,你见过吗?
图片尺寸660x695
肺炎链球菌
图片尺寸797x597
肺炎链球菌 (1)形态和染色:革兰染色阳性,菌体呈矛头状,成对排列,宽短
图片尺寸960x1280
电子显微镜下的肺炎球菌
图片尺寸533x371
肺炎球菌
图片尺寸1080x810
第三十八讲肺炎链球菌全方位的博弈
图片尺寸1080x1398
肺炎链球菌
图片尺寸1080x1439
这种肺炎疫苗,你真的了解吗?|性疾病|脑膜炎|双球菌_网易订阅
图片尺寸549x396
肺炎双球菌
图片尺寸300x268
标准的肺炎链球菌
图片尺寸1080x1441
肺炎链球菌的美丽
图片尺寸1080x1440
肺炎球菌最容易"伺机偷袭"5岁以下儿童!
图片尺寸1046x764
肺炎双球菌
图片尺寸640x480
肺炎链球菌op阳性图片一副
图片尺寸3264x2448
肺炎链球菌
图片尺寸214x220
> 健康信息 > 健康资讯除了高死亡率,侵袭性肺炎球菌还可能导致孩子
图片尺寸600x265
肺炎球菌疫苗
图片尺寸220x220
新肺炎链球菌
图片尺寸600x353
肺炎双球菌
图片尺寸272x264
肺炎链球菌(s. pneumoniae,图片来源于paramedicsworld.com)
图片尺寸510x384